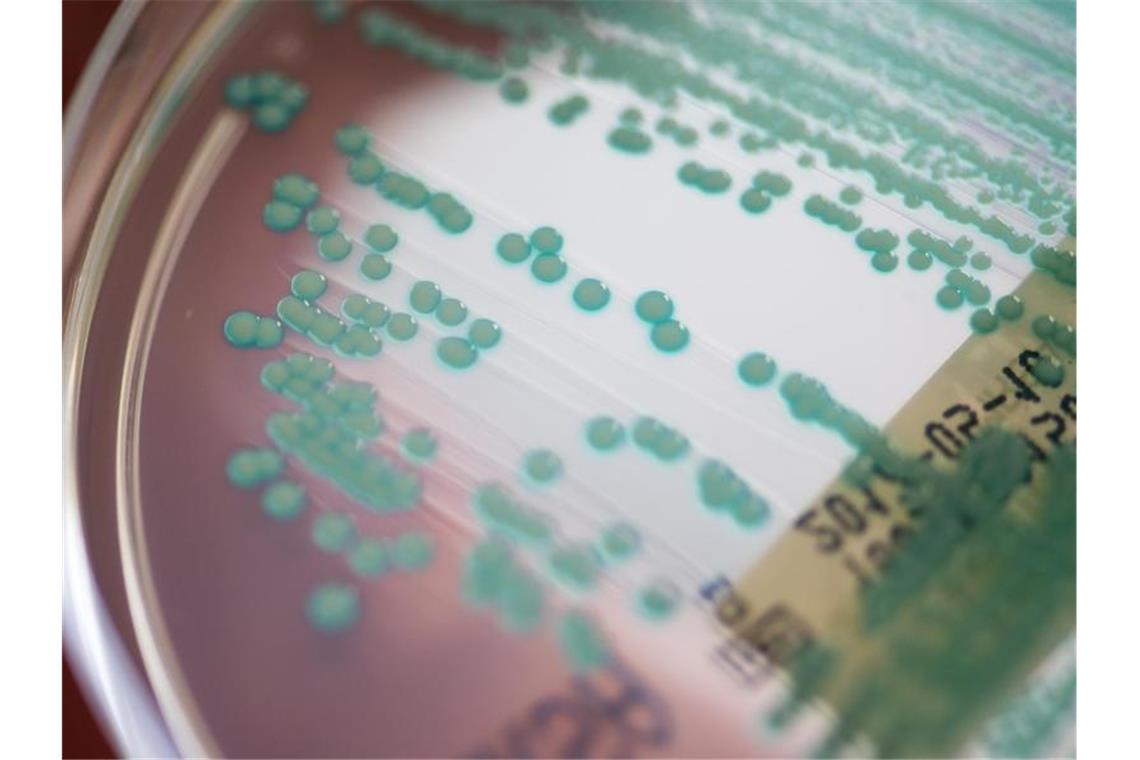

Umwelthilfe: Antibiotikaresistente Keime auf Geflügelfleisch
dpa Berlin. Die Deutsche Umwelthilfe hat hat Putenfleisch aus dem Supermarkt testen lassen. Auf mehr als einem Viertel der Proben wurden demnach Keime gefunden, gegen die Antiobiotika nicht mehr wirken.
Das Symbolfoto zeigt Keime in einer Petrischale im Labor. Foto: Armin Weigel/dpa
Die Deutsche Umwelthilfe (DUH) hat bei Testkäufen in zwei deutschen Discount-Ketten in mehr als einem Viertel der getesteten Putenfleisch-Portionen antibiotikaresistente Keime entdeckt.
In einer ganze Reihe von Proben seien sogar Keime gefunden worden, die gegen Reserve-Antibiotika resistent waren, sagte die DUH-Agrarexpertin Reinhild Benning am Dienstag in Berlin. Reserve-Antibiotika sollen eigentlich bei der Behandlung von Menschen als letztes Hilfsmittel im Kampf gegen Infektionen dienen, die durch multiresistente Bakterien ausgelöst werden.
Der Vorstandsvorsitzende des Weltärztebundes, Frank Montgomery, kritisierte bei der Präsentation der DUH-Untersuchung die breite Verwendung dieser Medikamente in der Nutztierhaltung und forderte schärfe Vorschriften der EU. „Wir brauchen die Beschränkung der Reserve-Antibiotika auf die Heilung bei Menschen.“ Stattdessen würden die Medikamente eingesetzt, um Mängel in der Tierhaltung auszugleichen.
Die DUH-Stichprobe ist nicht die ersten Untersuchung, die das Problem antibiotikaresistenter Keime in der Tierhaltung sichtbar macht. Auch andere Untersuchungen waren in der Vergangenheit bereits zu ähnlichen oder sogar schlechteren Ergebnissen gekommen.
Nach einem aktuellen Bericht mehrerer europäischer Gesundheits- und Lebensmittelbehörden ist der umstrittene Medikamenteneinsatz in der Nutztierhaltung allerdings tendenziell rückläufig. „Der Einsatz von Antibiotika ist zurückgegangen und bei zur Lebensmittelerzeugung genutzten Tieren erstmals geringer als beim Menschen“, teilte die Europäische Behörde für Lebensmittelsicherheit (Efsa) Ende Juni mit.
© dpa-infocom, dpa:210824-99-949109/2



